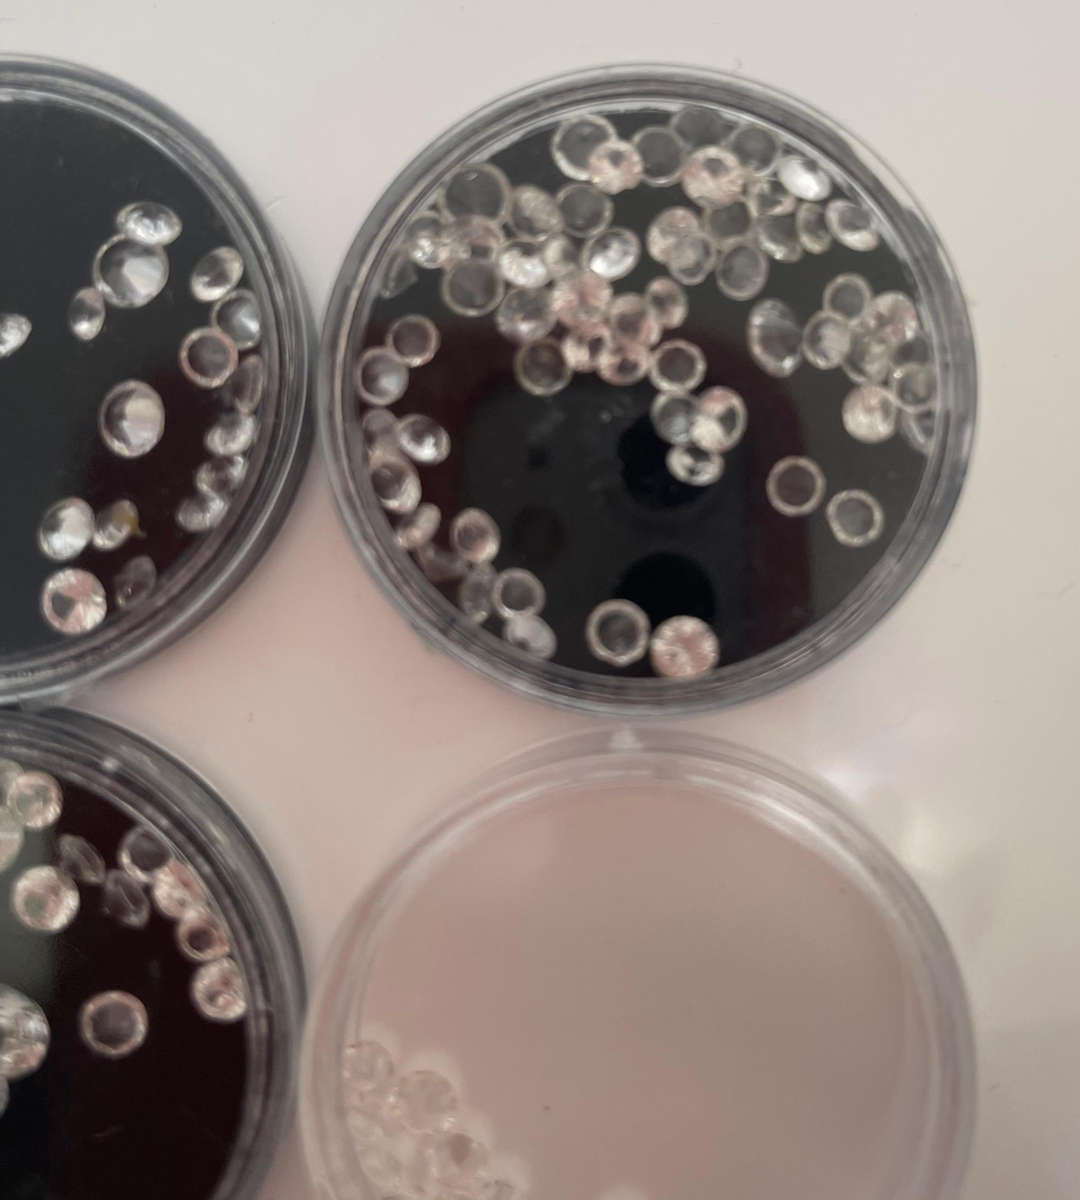
Over 100 Loose Diamond Simulants  Brilliant Cut  Removed from Gold Jewellery

+3
Over 100 Loose Diamond Simulants Brilliant Cut Removed from Gold Jewellery
Shipping
Free shipping is available from Twikkie 1 for all orders above R480.00, using one of our trusted couriers.
Check my rate
Check my rate
The seller has indicated that they will usually have this item
ready to ship within 3 business days.
Shipping time depends on your delivery address.
The most accurate delivery time will be calculated at checkout,
but in general, the following shipping times apply:
Standard Delivery
| Main centres: | 1-3 business days |
| Regional areas: | 3-4 business days |
| Remote areas: | 3-5 business days |
Seller
Get it now, pay later